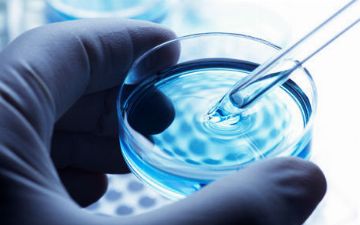
Узбекский акушер-гинеколог ответил на часто задаваемые вопросы про ЭКО

Все новости за 17 Июль 2021 года

Пандемия и полет Ричарда Брэнсона в космос: что еще нам предсказали Симпсоны?
17 июл. 2021 г., 13:22

Узбекистанец в погоне за хайпом в TikTok прокатился на крыше автомобиля Spark
17 июл. 2021 г., 12:31